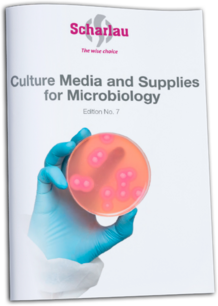

График работы:
Пн-Пт: с 09:00 до 17:00 Сб-Вс: выходной
Пн-Пт: с 09:00 до 17:00 Сб-Вс: выходной
Контакты:
Главная
Доставка
Новости
Контакты

+375 (29) 608-44-53
info@vonka.by
Реагенты для биохимических исcледований

Abcam

Abnova

Bio-Rad

Bio-Techne

BioLegend

Biomerieux

Corning

Eurofins Scientific

HiMedia Laboratories

IsolITW Reagents (PanReac AppliChem)ab

Macherey-Nagel

Merck

MyBioSource

New England Biolabs

Novus Biologicals

neoFroxx

Oxoid

PerkinElmer
Promega
Qiagen

R&D Systems

Santa Cruz Biotechnology

Scharlab

Tecan

Thermo Fisher Scientific

TOKTocrisU-e

VWR

Vazyme

Agdia

Lonza
У ВАС ОСТАЛИСЬ ВОПРОСЫ?
У ВАС ОСТАЛИСЬ ВОПРОСЫ?
Заполните форму и наш менеджер вас проконсультирует
Заполните форму и наш менеджер вас проконсультирует
Брошюры по биохимии и биотехнологии:

Реагенты для культуры клеток

Микроклональное размножение растений

NeoFroxx

Питательные среды для культур клеток

General Catalog biowest

Flyer Instant FBS from biowest

Flyer FreeAdd - Chemically defined substitute for serum from biowest

Flyer Mycoplasma biowest

Автоматический счётчик клеток Countess II

Оборудование и расходные материалы для мультиплексного анализа

RNAscope технология
Брошюры по биохимии и биотехнологии от компании Scharlau:
Культуральные среды для микробиологии

Микробиология для пищевой отрасли

Сухие культуральные среды

Культуральные среды в саше

Анализ пестицидов

Питательные среды для микробиологии
Брошюры по реактивам Merck:

Мониторинг чистых помещений

Определение микробиологической чистоты методом мембранной фильтрации

Прекращение выпуска микробиологических продуктов Merck с маркировкой CE

Питательные среды Heipha

Справочник по микробиологии Мерк

Новые цветомаркированные подложки MC Media Pads

Питательные среды ReadyPlate

Испытание лекарственных препаратов на стериальность и апирогенность
+375 (29) 608-44-53
info@vonka.by
VONKA
Наши контакты:
График работы:
Пн-Пт с 09:00 до 17:00
Сб-ВС выходной
Сб-ВС выходной
Пн-Пт с 09:00 до 17:00
Сб-ВС выходной
Сб-ВС выходной